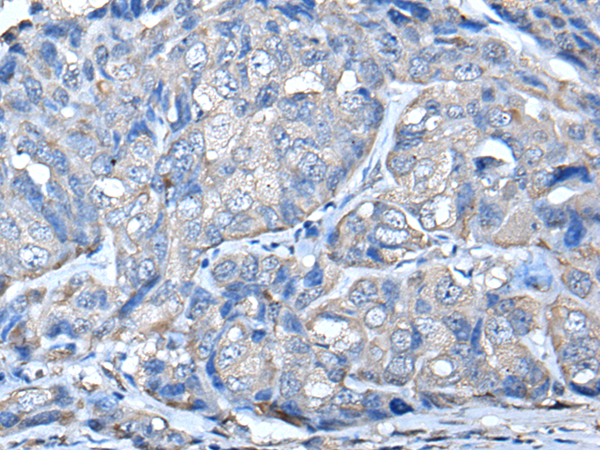

-
分类: 科研抗体货号: P01654别名: P2; MP2; FABP8; M-FABP应用: WB,IHC反应种属: Human, Mouse
-
分类: 科研抗体货号: P01652别名: BPIFE; HDLCQ9应用: IHC反应种属: Human, Mouse
-
分类: 科研抗体货号: P01679别名: LPTP; HEPTP; PTPNI; BPTP-4; LC-PTP应用: WB,IHC反应种属: Human, Mouse, Rat
-
分类: 科研抗体货号: P01647别名: PKR2; PRKAR2应用: WB,IHC反应种属: Human
-
分类: 科研抗体货号: P01657别名: KCT3; PORMIN; PORIMIN应用: IHC反应种属: Human
-
分类: 科研抗体货号: P01678别名: MOSP; PLIP; DUSP23; PNAS-129应用: WB反应种属: Human, Mouse, Rat
-
分类: 科研抗体货号: P01644别名: FDFACT1; FDFACT2应用: WB反应种属: Human
-
分类: 科研抗体货号: P01656别名: PENT; PNMTase应用: WB反应种属: Human, Mouse, Rat
-
分类: 科研抗体货号: P01677别名: RMD3; RMD-3; FAM82C; FAM82A2; ptpip51应用: WB,IHC反应种属: Human, Mouse, Rat
-
分类: 科研抗体货号: P01639别名: LANP; MAPM; PP32; HPPCn; PHAP1; PHAPI; I1PP2A; C15orf1应用: WB,IHC反应种属: Human

鄂公网安备42018502007531号
鄂公网安备42018502007531号

